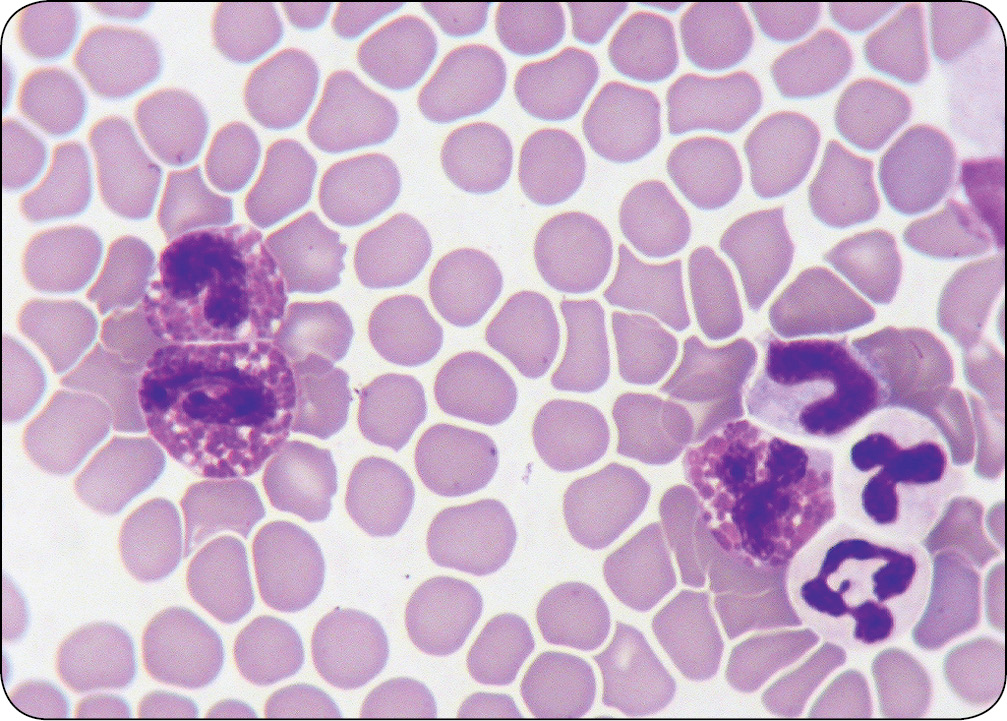
WWP_10_11_Janina_Lukaszewska_ZESPOLY_PARANOWOTWOROWE_RYC_2

Zespoły paranowotworowe Trudne przypadki
Opis przypadku 1
Suka, 7 lat, rasy owczarek collie. Od pewnego czasu spadek apetytu, osowiałość, częstomocz, poliuria, polidypsja, powiększenie obrysu brzucha. Przy omacywaniu jamy brzusznej stwierdzono obecność dużego tworu, prawdopodobnie śledziony. Dostępne węzły chłonne nie były powiększone. Wynik badania USG wykazał znaczne powiększenie śledziony o nieznacznie obniżonej echogenności oraz lekko powiększone węzły chłonne w przodobrzuszu. Innych zmian nie znaleziono. Wynik badania radiologicznego klatki piersiowej nie odbiegał od normy.

W morfologii stwierdzono bardzo znaczną leukocytozę (tabela 1, str. 40). W rozmazie krwi znaleziono: przesunięcie w lewo granulocytów obojętnochłonnych i kwasochłonnych do mielocytów włącznie. W niektórych jądra miały zmienione kształty (ryc. 1, 2). Występowały też erytroblasty (paranowotworowa erytroblastoza), mimo braku nasilonej regeneracji oraz komórki limfoidalne i blasty, sugerujące chłoniaka.
Wyniki badań biochemicznych, z wyjątkiem podwyższonego stężenia wapnia, nie odbiegały od wartości referencyjnych.
Badanie moczu: ciężar właściwy – 1,045; odczyn – 5,0; białko – 30 mg/dl; bilirubina, urobilinogen, glukoza nieobecne; w osadzie występowały zwyrodniałe nabłonki płaskie, często z wodniczkami, po 2-5 w polu widzenia; pojedyncze z głębszych warstw, bardzo ziarniste [...]
którzy są subskrybentami naszego portalu.
i ciesz się dostępem do bazy merytorycznej wiedzy!
Mogą zainteresować Cię również
POSTĘPOWANIA
w weterynarii


